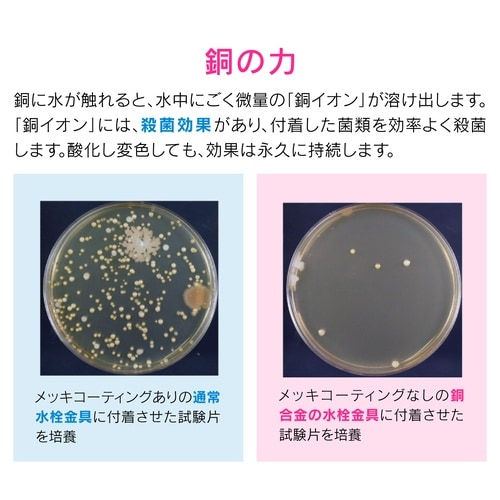
カクダイ GA−PB044 流用フタ

入数 1個 販売価格 ¥3,616 (税込)
三角コーナー・ゴミカゴ・スポンジラックの売れ筋ランキング
- ¥458(税込) (税込) 〜
- ¥1,122(税込) (税込)
- ¥385(税込) (税込)
- ¥990(税込) (税込)
- ¥550(税込) (税込) 〜
- ¥580(税込) (税込)
- ¥400(税込) (税込)
商品の特徴 |
排水口内径80ミリの排水トラップ用銅製排水口フタです。 |
|---|---|
商品仕様 |
|
メーカー情報 |
|
カタログ掲載ページ |
-/- |
| 注意事項 | ※【返品に関するご注意】この商品は直送品のため、お客様のご都合による返品はお受けできません。 |
|---|